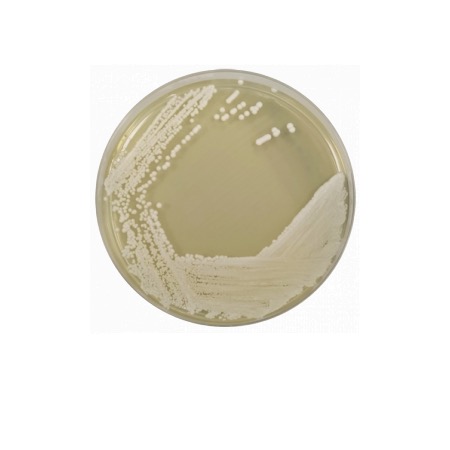

Yeast Extract Agar is a highly standardized, non-selective medium that supports the growth of a wide range of bacteria, yeasts, and molds. The Tryptone (pancreatic digest of casein) provides a rich source of nitrogen, amino acids, and peptides, while the Yeast Extract provides essential B-complex vitamins, amino acids, and growth factors that stimulate rapid microbial proliferation. The simplicity of the formula ensures that the medium does not favor any specific group of microorganisms, allowing for an accurate reflection of the total "culturable" population in a water sample. Bacteriological Agar acts as the solidifying agent. According to ISO 6222, the medium is used to assess the efficacy of water treatment processes and the general hygiene of water distribution systems.
Advantages
- ISO 6222 Compliance: Specifically formulated to meet the international standard for the enumeration of culturable microorganisms in water.
- High Nutrient Bioavailability: The combination of Tryptone and Yeast Extract ensures the recovery of stressed or fastidious organisms present in water samples.
- Temperature Versatility: Validated for use at both 36 °C (to detect flora associated with warm-blooded animals) and 22 °C (to detect natural water flora).
- Standardized Monitoring: Provides a reliable baseline for the microbiological quality control of public water supplies and bottled beverages.
- Excellent Clarity: The high quality of the components results in a clear agar, facilitating the counting of small or translucent colonies.
Technical specifications
| Catalogue number |
1049 |
| Brand |
Condalab |
| Application |
Enumeration of culturable microorganisms in water (ISO 6222) |
| Typical Composition (g/L) |
Tryptone (6.0); Yeast Extract (3.0); Bacteriological Agar (15.0) |
| Final pH (at 25 °C) |
7.2 ± 0.2 |
| Preparation |
24.0 g/L |
| Storage Temperature |
2 – 25 °C |
Available packaging options
| 1049 |
500 g plastic bottle |